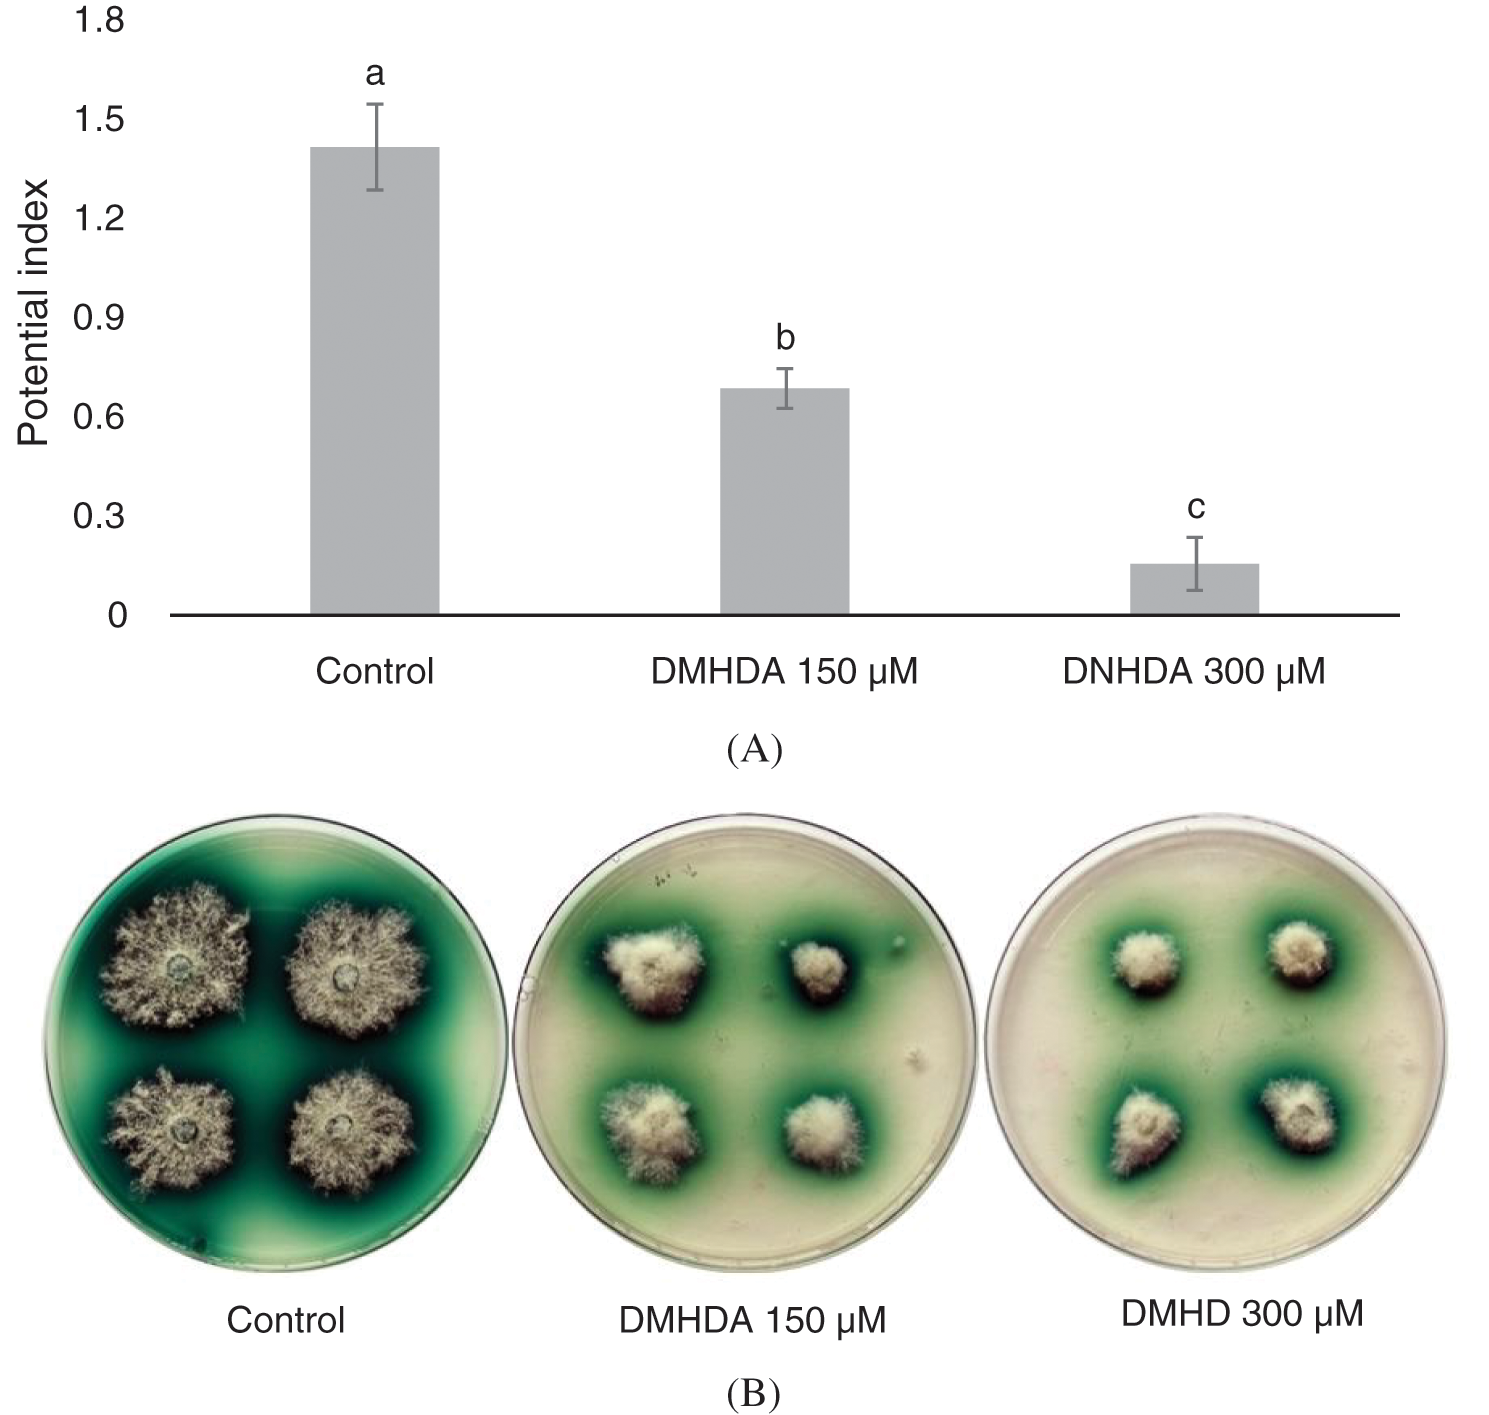
images

| Phyton-International Journal of Experimental Botany DOI:10.32604/phyton.2020.011402 | ![]() |
| Article |
Inhibitory Effect of N, N-Dimethylhexadecylamine on the Growth of White-Rot Fungus Trametes versicolor (L.) in Wood
1Universidad Michoacana de San Nicolás de Hidalgo, Facultad de Ingeniería en Tecnología de la Madera, Ciudad Universitaria, Morelia, 58030, México
2Instituto de Investigaciones Químico-Biológicas, Universidad Michoacana de San Nicolás de Hidalgo, Ciudad Universitaria, Morelia, 58030, México
*Corresponding Author: Crisanto Velázquez-Becerra. Email: cvelazquez@umich.mx
Received: 07 May 2020; Accepted: 14 July 2020
Abstract: Wood is an organic material that is a source of carbon of organisms called Wood-decay fungi, and to preserve the wood, various toxic compounds to man and the environment have been used. To analyze the effect of N,N-Dimethylhexadecylamine (DMHDA) on wood attacked by the rotting fungus Trametes versicolor L. We used an in vitro system to expose the fungus T. versicolor to different concentrations of the DMHDA (50, 150 and 450 µM). We quantified the diameter of mycelial growth and laccase activity, also, under these experimental conditions we studied morphological details of the organisms using different scanning equipment including scanning electron microscopy. The growth of T. versicolor exposed to DMHDA for 60 days, showed a concentration-dependent dose behavior, also, the electron microscopy analysis revealed that the morphology and mycelial density was affected by the DMHDA, showing a formation of atypical morphological and thickener folds. Finally, the pieces of wood treated with DMHDA and exposed to the fungus had a lower mass loss, after a period of 60 days of exposure, the values obtained were 0.7, 1.0 and 0.5 g of mass lost for the control, LoC and LoDMHDA treatments respectively. Wood-rot fungi have represented economic losses worldwide, the strategies used have been supported by toxic compounds for the environment. The DMHDA both in the Petri dish system and as a wood preservative was shown to significantly inhibit the growth of T. versicolor.
Keywords: Wood-decay fungi; N,N-dimethylhexadecylamine; wood preservative
Wood is a biodegradable lignocellulosic material with hygroscopic properties, used worldwide in construction, paper industry and power generation among many others [1]. However, due to its organic chemical constitution, wood is susceptible of attack by various xylophage organisms like bacteria, insects and fungi, the latter, through various enzymatic mechanisms degrade the main structural components which are lignin, cellulose and hemicelluloses, altering and compromising the physic, mechanical, chemical, anatomical and aesthetic properties of the material [2].
An important classification that xylophagous fungi have is based on the damage caused to the wood. The so-called brown, soft and white-rot fungi [3] are among the most important, the brown-rot fungi are caused by harmful xylophages, basidiomycetes like Serpula lacrymans, Coniophora puteana, Antrodia vaillantii, Lentinus lepideus, capable of efficiently degrade cellulose and hemicellulose, and change the structure of lignin. In the white-rot, basidiomycetes and some ascomycetes (e.g., Trametes versicolor, Trametes hirsuta and Schizophyllum commune) preferably feed on lignin, although they can also degrade and use cellulose as a carbon source. Ascomycete organisms that cause soft-rot (e.g., Chaetomium Globesum, Monodictys putredinis, Hypocrea muroiana, Cryphonectria parasitica and Fusarium oxysporum) grow on the inner lumen of the secondary cell wall in the wood, mainly affecting cellulose by altering the structure of lignin, and thus induce a characteristic whitening of lignocellulosic material [4,5].
For this reason, and as a strategy to prolong the useful life of the material due to the damage of these organisms, chemical compounds and various treatments that favor their preservation have been used in the wood industry. Due to its effectiveness, among the most commonly used wood treatments are mixtures of mineral salts with organic elements, where their classification depends on their nature and function: Creosote oil, oil-soluble (Pentachlorophenol/C6HCI5O, Naphthenates, Sodium Pentachlorophenate/C6C15NaO, Tributyltin oxide/C24H54OSn2, Copper Quinolinolate), water-soluble (Arsenic Copper Ammoniacal/AS2 50, 20%, Cu 49.80%, Copper Chrome Arsenicals/AS2O5–5H2O 56%, SO4, Cu-2H2O 335, C2O7K2 11%, copper chrome boron/CuO, Cr2O3H3BO3, boron compounds) and other salts (Chromium Zinc Chlorine/CrO3 20%, C12Zn 80% and Fluorine-Chromium-Arsenic-Phenol) [6,7].
However, the aforementioned compounds, due to their chemical formulation have generated doubts in their use, since, despite the proven efficacy, most of the referred products are classified as toxic and dangerous to humans and the environment [8], even, in some developed countries its use has been banned permanently [9,10]. One of the most commonly used chemical preservatives is chromated copper arsenate (CCA salts) and due its toxicity to living beings, since January 2004, the United States Environmental Protection Agency prohibited it to treat wood at homes. Also, creosote oil has represented an environmental hazard, due to the high content of polycyclic aromatic hydrocarbons, associated with serious problems of dysfunction and renal cancer [11,12].
There are treatments applied to wood that do not represent an environmental and/or human health problem, for example, thermal-treatments are known to improve the properties of durability and dimensional stability of the material. However, because the procedure used exposes the wood to a high temperature for prolonged periods of time, the mechanical and structural properties are compromised, and the effectiveness and protection time it provides is not comparable to chemical treatments previously mentioned [13–15].
There is evidence that organic compounds effectively inhibit the growth of deleterious fungi. Some soil microbial communities produce volatile organic compounds (VOCs) such as trimethylamine, benzaldehyde and N,N-dimethyloctylamine, which inhibit the growth of the fungi Phaeomoniella chlamydospora, Paecilomyces lilacinus and Clonostachys rosea [16]. Similarly, the bacteria Bacillus amyloliquefaciens SQR-9 produces 2-nonanone, 2-undecanone, 2-tridecanone, nonanal and undecanal that inhibit the growth of Ralstonia solanacearum in vitro conditions [17]; Bacillus subtilis CF-3 produces 2,4-di-tert-butylphenol and 1-octanol and benzothiazole that prevent the growth of Monilinia fructicola and Colletotrichum gloesporoides [18]; Bacillus atrophaeus HAB-5 produces chloroacetic acid, tetradecyl esters, octadecane, hexadecanoic, methyl ester which show significant antifungal activity against Collectotrichum gloeosporioides [19].
In our work group, a chromatographic analysis of the profile of volatile compounds from the bacterial strain Arthrobacter agilis UMCV2 was found to release the amino lipid N,N-Dimethylhexadecylamine [20]. This compound can inhibit the growth of phytopathogens Botrytis cinerea and Phytophthora cinnamomi [21] and isolated xylophages such as Hypocrea sp. (UMTM3) and Fusarium sp. (UMTM13) [22].
In microbial ecosystems, compounds of high biological value have been identified with the potential to b{e used as biological control or preservatives of various organic materials. The aim of this work was to study the preservation sufficiency of the N,N-Dimethylhexadecylamine on wood susceptible to attack by the white-rot fungi Trametes versicolor (L.), with the purpose of providing information that shows its use in protecting lignocellulosic materials.
2.1 Effect of N,N-dimethylhexadecylamine on the Growth of Trametes versicolor (L.)
The White-rot fungus Trametes versicolor (L.) was donated by the Department of Cellulose Wood and Paper of the University of Guadalajara Jalisco, Mexico. (http://www.cucei.udg.mx/es/directorio/Departamento-de-Madera-Celulosa-y-Papel).
We perform a bioassay with different concentrations of DMHDA to challenge the white-rot fungus T. versicolor in a Petri dish system. We prepared a decreased culture medium (PDA-d) with 9.75 g/L of Potato Dextrose Agar (PDA) (BD Bioxon) and 11.25 g/L of Bacteriology Medium Agar (BD Bioxon). The mixture was sterilized using an autoclave (Aesa, Model CV-300) at 120°C/15 lbs of pressure for 15 min. Under sterile conditions, the fungal culture medium was allowed to cool to approximately 45°C, then we added the DMHDA (CAS Number 112-69-6, Cat. No. 40460, Sigma-Aldrich) at concentrations of 50, 150 and 450 µM, and the control medium was without DMHDA (using turpentine to dilute 1:1). Once the culture medium was prepared, it was inoculated with 20 mg of mycelium (T. versicolor) previously grown in PDA-d medium. The experiment was carried out in a microbiological incubator (Felisa, Zapopan, Jalisco, México) at 28°C for 8, 15, 30, 45 and 60 days, and the growth (diameter) and morphology of the fungus mycelium were analyzed in those sampling times [23,24].
2.2 Microscopic Analysis of the Effect of the DMHDA on Trametes versicolor (L.)
The microscopic images were obtained at the Institute for Research in Metallurgy and Materials (www.iim.umich.mx), using a scanning electron microscope (JOEL brand model JSM6400) at 1000 and 3000x. Using replicas of the treatments previously tested, and with the help of a dissecting needle, samples were taken from the mycelium corresponding to zero, 50 and 150 µM treatments of DMHDA, then the mycelium was placed on a glass slide and using a metal coating equipment of samples (EDWARDS E306A), a copper bath was applied to the samples for 20 min for subsequent visualization. Finally, the general morphological and structural characteristics of the T. versicolor mycelium were evaluated [25–27].
2.3 Preservative Effect of the DMHDA on Wood Pieces Exposed to Trametes versicolor (L.)
Wood pieces of Pinus sp. from a forest located in the municipality of Ichaqueo Michoacán, México (UTM 14Q 275505.56 m East and 2165602.14 m North) were obtained and adapted according to the protocol of the American Wood Protection Association [28], the wood pieces had dimensions of 2.0 × 2.0 × 2.5 cm. Using a simple immersion procedure, the wood pieces were treated, soaking them for 48 hours in a) linseed oil (LoC), b) linseed oil with 450 µM DMHDA (LoDMHDA), the control group had no linseed oil or DMHDA. After the incubation time, the pieces were dried at room temperature (25°C) until constant weight was obtained.
Based on the work of Green et al. [29] we added 100 g of Peat Moss-Agrolite, (9:1 ratio) previously autoclaved (120°C/15 lbs of pressure for 30 min) to plastic containers of 326 ml. Then in each bottle we put the feeding strips (3.0 × 0.28 × 34.0 mm) of the fungus and we inoculated them with T. versicolor using a 5 mm disc. Finally, the wood pieces treated were placed in a microbiological incubator at 28°C in constant dark for 60 days [28].
After the 60-day incubation, the damage of the wood pieces was calculated according to the mass loss and internalization of the mycelium according to the NTC 1127 and UNE EN 350-1 standards present in the AWPA [28].
Using the wooden pieces of the Control, LoC (linseed-oil) and LoDMHDA (linseed-oil with DMHDA) treatments, and taking the work of Prislan et al. [30] as a reference, the samples were conditioned to carry out the anatomical cuts, which comprised placing the wood pieces together with paraffin blocks in an incubator at 45°C for 24 h, then the wood pieces embedded in paraffin were left to stand at room temperature (25°C for 2 h). Using a microtome (RadicalTM Model RMT30) anatomical cuts 8–10 µm thick were made in a transverse direction of the wood pieces for each treatment.
The anatomical cuts of the wood pieces were made transversely, and then the histological sections were bleached with a 20% sodium hypochlorite solution for 7 min, then washed with distilled water until bleach residues were completely removed. We stained the sections with astral blue for 12 hours until uniform dyeing was achieved. The sections were washed again with 60% alcohol to remove the excess of the dye, then gradually dehydrated in alcohol, starting at 70, 80 and 96% for one hour, next, the samples were placed in absolute alcohol for 5 min and clarified with toluene, finally, the sections observed in an optical microscope (Zeigen, Mexico City, Mexico) with 10 and 40x lenses [3].
2.6 Qualitative Determination of the Laccase Activity in Trametes versicolor (L.)
To know the effect of the compound DMHDA on the laccase activity (EC 1.10.3.2) of Trametes versicolor, the enzymatic activity was evaluated under a solid fermentation system with 150 and 300 µm DMHDA, and a Control without DMHDA. Using the 2,2′-azino-bis [3-ethylbenzothiazoline-6-sulfonic] acid reaction test (ABTS) [31] in a basal medium (LBM) with the following composition (g/L): 1.0 g of KH2PO4; 0.5 g of C4H12N2O6; 0.5 g of MgSO4·7H2O; 0.01 g of CaCl2·2H2O; 0.01 g of yeast extract; 0.001 g of CuSO4·5H2O; 0.001 g of Fe(SO4)3, and 0.001 g of MnSO4. Aliquots of 100 ml containing the LMB medium were prepared and supplemented with 0.1% ABTS and 1.6% agar, the mixture was autoclaved at 121°C for 15 min and 1 ml of 20% (w/v) a sterilized glucose solution was added.
The prepared medium was transferred to Petri dishes and once the medium was solidified, it was inoculated with a 5 mm diameter propagule of T. versicolor (previously grown in PDA medium), the Petri dishes were incubated at 28°C for eight days [30,32]. After this period, the diameter of the T. versicolor colony and the diameter of the ABTS oxidation halo were quantified, with both values the power index (IP) was calculated, dividing the diameter of the oxidation halo by the diameter of mycelium growth [33].
All experiments included at least four Petri plates per treatment and were two to three times independently reproduced. The results corresponding to the growth of T. versicolor were analyzed with the software STATISTICA 7.0 (TIBCO Statistica, Palo Alto, CA) using an ANOVA and subsequent Tukey test (p < 0.05).
3.1 Trametes versicolor (L.) Growth Exposed to DMHDA
The behavior shown by the white rot fungus T. versicolor using the PDA-decreased culture medium revealed an adequate adaptation, in the control treatment (free of DMHDA) the fungus grew ad libitum over 8 days, covering the entire Petri dish. However, in the culture medium, the addition of DMHDA showed an interesting dose-dependent behavior of concentration and time, the lowest concentration tested (50 µM DMHDA) after 8 days of exposition showed an important inhibition of mycelial growth. After 60 days, the inhibition decreases, and is equal to the control, with no statistical difference (Fig. 1, squares). An exposition of 150 µM DMHDA for 8 days showed a sustained and statistically significant inhibition, and after 60 days the growth of T. versicolor was different from the control group (Fig. 1, triangles).

Figure 1: Mycelial growth of Trametes versicolor exposed to different concentrations of N,N-Dimethylhexadecylamine compound (DMHDA 50, 150 and 450 µM) for a period of 60 days. Letters are used to indicate means that differ significantly by a Tukey’s multiple range test (p < 0.05; n = 5)
Also, the bioassay revealed that during the period evaluated, T. versicolor incubated in a PDA medium with 450 µM DMHDA limits its growth to the extent that, by re-inoculating the organism in a DMHDA free medium, cannot develop any longer, unlike treatments with lower concentrations (Fig. 1 exes; Figs. 2a and 2b).

Figure 2: Mycelial growth of Trametes versicolor exposed to different concentrations of N,N-Dimethylhexadecylamine compound (DMHDA 50, 150 and 450 µM) in a Petri dishes system. The assay was maintained for a period of 60 days and subsequently re-inoculated in medium DMHDA-free for 8 days
3.2 Micrograph of Trametes versicolor (L.) Grown in Different DMHDA Concentrations
The scanning electron microscopy analysis revealed that DMHDA affectedthe morphology and density of mycelium in T. versicolor. Fig. 3 shows a subtle thickening and deformation of the mycelium with 50 µM DMHDA (Figs. 3a and 3b) and with 150 µM DMHDA a greater morphological change is noticed compared to the control, presenting a thickening (3 µm) and clear mycelial roughness, together with a significant amount of atypical folds in its morphology (Figs. 3a and 3c).

Figure 3: Micrographs of Trametes versicolor exposed to N,N-Dimethylhexadecylamine compound (DMHDA), where it is observed: Image A shows the morphology of the fungus in DMHDA-free conditions (Control) at 1000x (A) and 3000x (A1). Image B shows the morphology under DMHDA conditions at 50 µM, 1000x (B) and 3000x (B1), and under conditions of DMHDA 150 µM, 1000x (C) and 3000x (C1)
3.3 Effect of DMHDA on Laccase Activity of Trametes versicolor (L.)
DMHDA was able to decrease the production of laccase in solid fermentation with power indexes of 1.4, 0.6 and 0.1 for the control, 150 and 300 µM DMHDA respectively (Fig. 4a). T. versicolor with enzyme activity showed a green halo around the mycelium (Fig. 4b). It is also important to note that the 450 µM DMHDA treatment showed no mycelial growth, which is why it was not considered for this trial (Fig. 2).
Figure 4: (A) Potential Index (PI) of the Trametes versicolor fungus exposed to different concentrations of N,N-Dimethylhexadecylamine compound (DMHDA). (B) Growth of the fungus exposed to DMHDA 150 and 300 µM, observing the oxidation halo diameter of the ABTS (in green). Letters are used to indicate means that differ significantly by a Tukey’s multiple range test (p < 0.05; n = 5)
3.4 Preservative Effect of DMHDA on Wood Pieces Exposed to Trametes versicolor (L.)
The wood pieces treated with DMHDA showed a potential use as a wood preservative. Wood pieces exposed to T. versicolor with the LoDMHDA treatment were the ones that lost the least weight, after a 60-day exposure, the mass lost was 0.7, 1.0 and 0.5 g for the control, LoC and LoDMHDA groups (Fig. 5a). Fig. 5b shows representative images of the wood pieces tested, where the mycelium of the fungus grows on the surface of the wood, however, not in all the treatments the mycelium invades the interior of the timber tissue.

Figure 5: (A) Weight loss of the pieces of wood exposed to Trametes versicolor fungus, the treatments correspond to Control, LoC (linseed-oil) and LoDMHDA (linseed-oil with DMHDA 450 µM). (B) Representative images of the wood pieces of the treatments shown above. Letters are used to indicate means that differ significantly by a Tukey’s multiple range test (p < 0.05; n = 10)
The mycelial internalization of T. versicolor in timber tissue of the control, LoC and LoDMHDA groups was analyzed microscopically for structural damage and/or growth, observing an evident mycelial presence on the tracheid of the Control treatment (Fig. 6a). It is important to highlight that in the LoC and LoDMHDA treatments no evidence of fungal growth was found (Figs. 6b and 6c).

Figure 6: Microscopic images corresponding to transversal sections of the wood tissue exposed to Trametes versicolor. The images show the presence of mycelium (red arrows) in the Control treatments at 10x (A) and 40x (A1), LoC (linseed-oil) 10x (B) and 40x (B1) and LoDMHDA (linseed-oil with DMHDA 450 µM) 10x (C) and 40x (C1)
The optimal growth conditions reported for T. versicolor (synonym Coriolus versicolor [34]), in Petri dish systems with PDA in concentrations that favor its development already have been reported, but the testing in a system using wood (Pinus pseudostrobus Lindl.) as a carbon source, the fungus decreases its growth significantly (this work). When conditions cease to be favorable and inter-microbial competition is high, fungi direct their metabolic effort to mycelial development, thus covering a greater surface area of nutritional absorption and exploring the nutritional or xenobiotic resources of the environment [35]. In this work, by using a PDA-diminished medium (PDA-d), we tried to simulate the natural conditions of the development of T. versicolor, which, despite the low amount of nutrients available in the culture medium. Reports made by Barreto et al. [27] and Meena et al. [36] mention that T. versicolor is characterized by presenting a high growth rate in unfavorable conditions, maintaining a high reproduction rate and adopting different strategies to achieve colonization in a nutrient limiting environment.
DMHDA is an amino lipid of 16 carbon atoms in the lipid group, and the mechanism by which it inhibits the growth of some phytopathogens and how this compound acts on the cell membrane or other organelles of T. versicolor or any other microorganism has not yet been determined. But there are works with compounds of similar chemical structure (fatty acids) that provide an important idea of the effect on the fungal cell membrane [37,38], the evidence points to a toxic and dependent effect on the length of the hydrocarbon chain and the presence of the amino group [20,21].
The synthesis of organic compounds from microorganisms that inhibit the growth of pathogens is known, and there is a significant amount of identified compounds, for example; various strains of Pseudomonas produce 2,4-diacetylphloroglucinol, phenazine-1-carboxylic acid and pyrrolnitrin that limit the growth of Rhizoctonia spp. and Fusarium spp.
Bacillus amyloliquefaciens CEIZ11 synthesizes various lipopeptides like iturin, surfactin and fengycin, which suppress the growth of the phytopathogens Fusarium oxysporum, Pythium aphanidermatum, Botrytis cinerea, Alternaria alternata and Aspergillus niger [9,39–42]. Biocomposites of similar chemical structure, for example, the one produce by Bacillus subtilis G8 strain (1-Hexadecanamine, N,N-dimethyl), suppresses the growth of the phytopathogenic ascomycetes Sclerotinia sclerotiorum, Botrytis cinerea, Alternaria solani [43,44]. VOCs from bacteria like 2-nonanone and 2-undecanone inhibit the growth of Sclerotinia sclerotiorum, causing alterations in the hyphae, probably due to the condensation and alteration in the chemical structure of chitin [45]. There are other bioactive metabolites of bacterial origin (derived from Bacillus subtilis) that under in vitro conditions, the synthesis of lipopeptides responsible for a greater antifungal activity towards multiple plant pathogens was detected [46,47].
The inhibition or control of the growth of pathogenic organisms through compounds with antibiotic or toxic activity, can act at different levels, either affecting a metabolic pathway, degrading some biomolecule of the cell membrane or affecting some essential compounds responsible for supporting important vital functions. In this sense, the information generated in this study did not reveal the reason why the DMHDA inhibited the growth of T. versicolor, but the fact that we now know that the DMHDA limits the laccase activity of the fungus is of great importance, since we know that fungal activity is involved in its nutrition. The ability of Trametes versicolor or white-rot fungus to degrade lignin depends on the production of extracellular enzyme systems like peroxidases (EC 1.11.1.7) and laccases (EC 1.10.3.2). These ligninolytic enzymes enhance the fungus ability to degrade a wide variety of organic compounds. However, previous studies have revealed that there is a decrease in laccase activity due to exposure to fungicides, which suggests that the expression of this enzyme may be an indicator of the presence of compounds toxic to Trametes [48]. In this work, it was possible to see how the exposure to DMHDA inhibited laccase activity, suggesting that the compound may generate cytotoxicity in the fungus. However, we know that a study focused on knowing the signaling path by which this phenomenon occurs is necessary.
Morphological changes seen in the microscopic images (Figs. 3b and 3c) show significant fungal stress, the data correspond to the effect seen using antifungal fatty acids produced by Pseudozyma flocculosa (cis-9-Heptadecenoic acid), which act intercalating cis-9-Heptadecenoic acid molecules between the fungal membrane, which promotes fluidity depending on the buffering capacity (sterol content), reducing membrane homeostasis and causing conformational changes in membrane proteins, increased permeability and eventually cytoplasmic disintegration [23,49]. The antifungal mechanisms of free fatty acids can fractionate the cell membrane, especially in cells with a low sterol content; they can inhibit protein myristoylation and subsequent selection of cell membrane proteins, they can slow down β-oxidation, triacylglycerol synthesis and sphingolipid synthesis, and limit topoisomerase activity [50].
The adaptation seen in T. versicolor with 50 µM DMHDA over a 60-day period was interesting, however, at 150 and 450 µM DMHDA failed to adapt. Due to the evolutionary strategy of xylophagous fungi that have developed, oxidative and hydrolytic systems are particularly widespread, which defines the adaptation of these fungi to diverse substrates [51]. The fungus Aspergillus nidulans, through coupled assimilation mechanisms, can carry out ammonia fermentation to tolerate low oxygen [52]. With the physicochemical characteristics of DMHDA (volatility at room temperature) and the short exposure period (60 days), the fungus T. versicolor was able to adapt to the minimum condition tested, under similar experimental conditions, 50 µM DMHDA had no inhibitory effect on the growth of Hypocrea sp. and Fusarium sp. [22].
The N,N-dimethylhexadecylamine concentrations used in this work significantly inhibit the growth of the fungus, to the extent of repressing it in its entirety (450 µM). The dose response growth curve indicates that the inhibition of the fungus began with 50 µM DMHDA and increased with higher concentrations of DMHDA. However, transferring this result to the soil-block test system was not effective in inhibiting fungal growth. The mixture of 450 µM DMHDA and linseed oil (LoDMHDA) to treat wood pieces of Pinus sp. after the exposure of T. versicolor for 60 days caused a lower mass loss in comparison with the control group. Wood treated with linseed oil has a water-repellent capacity by keeping it moisture free and limited microbial growth. Treatments based on impregnation or application of water-repellent substances such as oils, resins, waxes or coatings, protection of the cell luminaire without changing the properties of the cell wall are of commercial distribution and use. Control of the humidity by saturating the middle lamella with the superficial application of non-polar substances could be classified as a modification of the wood, which is another preservation strategy [24] in our work, the mixture between linseed oil and DMHDA could have achieved a synergetic inhibitory effect, limiting fungal development by two different mechanisms.
The direct exposure of organic solvents to microorganisms can inhibit their growth, the solvent used to dilute DMHDA in linseed oil was turpentine. It is important to mention that turpentine did not inhibit the growth of T. versicolor, because it was volatilized under the experimental conditions tested. Ahmed et al. [53] used pine tar (turpentine as the main component) [54] to impregnate Populus tremula and Betula pubescens wood, and improved water repellency and dimensional stability but did not change the growth resistance of fungi Aspergillus, Rhizopus and Penicillium.
The mycelial micrograph of T. versicolor exposed to 150 µM DMHDA showed a growth of the fungus under metabolic stress, and at 450 µM it showed a fungicidal effect, preventing the growth of xylophagous. Finally, the DMHDA mixed with linseed oil promises to be an alternative to preserve low durability wood by showing important technical advantages such as its ease of application and potential to be used in impregnating wood for indoor use, also the Agency for Toxic Substances and Disease Registry [55] has not listed it as a dangerous substance to human health.
In this work it was found that the DMHDA tested in a Petri dish system significantly inhibited the growth of the white-rot fungi Trametes versicolor, likewise, it was also found that, when used as a wood preservative (Soil-Block test) showed a clear suppressive effect on fungal growth.
Authors Contribution: WMM and EDR performed the experiments and drafted the manuscript. MMP, AMR and EAP have drafted the manuscript. CVB wrote and edited the manuscript.
Funding Statement: The authors received no specific funding for this study.
Conflicts of Interest: The authors declare that they have no conflicts of interest to report regarding the present study.
References
1. Pizzi, A. (2016). Wood products and green chemistry. Annals of Forest Science, 73(1), 185–203. DOI 10.1007/s13595-014-0448-3.
2. Meyer, L., Brischke, C. (2015). Fungal decay at different moisture levels of selected European-grown wood species. International Biodeterioration & Biodegradation, 103, 23–29. DOI 10.1016/j.ibiod.2015.04.009. [Google Scholar] [CrossRef]
3. Krah, F. S., Bässler, C., Heibl, C., Soghigian, J., Schaefer, H. et al. (2018). Evolutionary dynamics of host specialization in wood-decay fungi. BMC Evolutionary Biology, 18(1), 1–13. DOI 10.1186/s12862-018-1229-7. [Google Scholar] [CrossRef]
4. Janusz, G., Pawlik, A., Sulej, J., Świderska, B. U., Jarosz, W. A. et al. (2017). Lignin degradation: Microorganisms, enzymes involved genomes analysis and evolution. FEMS Microbiology Reviews, 41(6), 941–962. DOI 10.1093/femsre/fux049. [Google Scholar] [CrossRef]
5. Liers, C., Arnstadt, T., Ullrich, R., Hofrichter, M. (2011). Patterns of lignin degradation and oxidative enzyme secretion by different wood-and litter-colonizing basidiomycetes and ascomycetes grown on beech-wood. FEMS Microbiology Ecology, 78(1), 91–102. DOI 10.1111/j.1574-6941.2011.01144.x. [Google Scholar] [CrossRef]
6. Freeman, M. H., Kitchens, S. C., Amburgey, T. L. (2013). Wood preservative systems containing copper and borates: efficacy and synergy. American Wood Protection Association, 109, 226–239. [Google Scholar]
7. Singh, A. P., Singh, T. (2014). Biotechnological applications of wood-rotting fungi: A review. Biomass and Bioenergy, 62, 198–206. DOI 10.1016/j.biombioe.2013.12.013. [Google Scholar] [CrossRef]
8. Civardi, C., Schwarze, F. W. M. R., Wick, P. (2015). Micronized copper wood preservatives: An efficiency and potential health risk assessment for copper-based nanoparticles. Environmental Pollution, 200, 126–132. DOI 10.1016/j.envpol.2015.02.018. [Google Scholar] [CrossRef]
9. Costa, M., Klein, C. B. (2008). Toxicity and carcinogenicity of chromium compounds in humans. Critical Reviews in Toxicology, 36(2), 155–163. DOI 10.1080/10408440500534032. [Google Scholar] [CrossRef]
10. Sandberg, D., Kutnar, A., Mantanis, G. (2017). Wood modification technologies–A review. Iforest-Biogeosciences and Forestry, 10(6), 895–908. DOI 10.3832/ifor2380-010. [Google Scholar] [CrossRef]
11. Campo, L., Addario, L., Buratti, M., Scibetta, L., Longhi, O. et al. (2006). Biological monitoring of exposure to polycyclic aromatic hydrocarbons by determination of unmetabolized compounds in urine. Toxicology Letters, 162(2–3), 132–138. DOI 10.1016/j.toxlet.2005.09.024. [Google Scholar] [CrossRef]
12. Ravnskov, U. (2005). Experimental glomerulonephritis induced by hydrocarbon exposure: A systematic review. BMC Nephrology, 6(1), 163. DOI 10.1186/1471-2369-6-15. [Google Scholar] [CrossRef]
13. Gérardin, P. (2016). New alternatives for wood preservation based on thermal and chemical modification of wood—A review. Annals of Forest Science, 73(3), 559–570. DOI 10.1007/s13595-015-0531-4. [Google Scholar] [CrossRef]
14. Lee, S. H., Ashaari, Z., Lum, W. C., Halip, J. A., Ang, A. F. et al. (2018). Thermal treatment of wood using vegetable oils: A review. Construction and Building Materials, 181, 408–419. DOI 10.1016/j.conbuildmat.2018.06.058.
15. Welzbacher, C. R., Wehsener, J., Rapp, A. O., Haller, P. (2008). Thermo-mechanical densification combined with thermal modification of Norway spruce (Picea abies Karst) in industrial scale-Dimensional stability and durability aspects. Holz Als Roh-und Werkstoff, 66(1), 39–49. DOI 10.1007/s00107-007-0198-0. [Google Scholar] [CrossRef]
16. Chuankun, X., Minghe, M., Leming, Z., Keqin, Z. (2004). Soil volatile fungistasis and volatile fungistatic compounds. Soil Biology and Biochemistry, 36(12), 1997–2004. DOI 10.1016/j.soilbio.2004.07.020. [Google Scholar] [CrossRef]
17. Raza, W., Wei, Z., Ling, N., Huang, Q., Shen, Q. (2016). Effect of organic fertilizers prepared from organic waste materials on the production of antibacterial volatile organic compounds by two biocontrol Bacillus amyloliquefaciens strains. Journal of Biotechnology, 227, 43–53. DOI 10.1016/j.jbiotec.2016.04.014. [Google Scholar] [CrossRef]
18. Gao, H., Li, P., Xu, X., Zeng, Q., Guan, W. (2018). Research on volatile organic compounds from Bacillus subtilis CF-3: biocontrol effects on fruit fungal pathogens and dynamic changes during fermentation. Frontiers in Microbiology, 9, 1–15. DOI 10.3389/fmicb.2018.00001. [Google Scholar] [CrossRef]
19. Rajaofera, M. J. N., Wang, Y., Dahar, G. Y., Jin, P., Fan, L. et al. (2019). Volatile organic compounds of Bacillus atrophaeus HAB-5 inhibit the growth of Colletotrichum gloeosporioides. Pesticide Biochemistry and Physiology, 156, 170–176. DOI 10.1016/j.pestbp.2019.02.019. [Google Scholar] [CrossRef]
20. Velázquez, B. C., Macías, R. L. I., López, B. J., Altamirano, H. J., Flores, C. I. et al. (2011). A volatile organic compound analysis from Arthrobacter agilis identifies dimethylhexadecylamine, an amino-containing lipid modulating bacterial growth and Medicago sativa morphogenesis in vitro. Plant and Soil, 339, 329–340. DOI 10.1007/s11104-010-0583-z. [Google Scholar] [CrossRef]
21. Velázquez, B. C., Macías, R. L. I., López, B. J., Flores, C. I., Santoyo, G. et al. (2013). The rhizobacterium Arthrobacter agilis produces dimethylhexadecylamine, a compound that inhibits growth of phytopathogenic fungi in vitro. Protoplasma, 250, 1251–1262. DOI 10.1007/s00709-013-0506-y. [Google Scholar] [CrossRef]
22. Orozco, M. M. C., Valencia, C. E., López, A. P., Martínez, P. M., Velázquez, B. C. (2015). La bacteria Arthrobacter agilis UMCV2 y diversas aminas inhiben el crecimiento in vitro de hongos destructores de la madera. Revista Argentina de Microbiología, 47, 219–228. DOI 10.1016/j.ram.2015.06.005. [Google Scholar] [CrossRef]
23. Guerrero, D. G., Martínez, V. E., de la Torre Almaráz, R. (2011). Cultivation of Trametes versicolor in Mexico. Micologia Aplicada International, 23, 55–58. [Google Scholar]
24. Humar, M., Lesar, B. (2013). Efficacy of linseed-and tung-oil-treated wood against wood-decay fungi and water uptake. International Biodeterioration and Biodegradation, 85, 223–227. DOI 10.1016/j.ibiod.2013.07.011. [Google Scholar] [CrossRef]
25. Bari, E., Nazarnezhad, N., Kazemi, S. M., Ghanbary, M. A. T., Mohebby, B. et al. (2015). Comparison between degradation capabilities of the white rot fungi Pleurotus ostreatus and Trametes versicolor in beech wood. International Biodeterioration and Biodegradation, 104, 231–237. DOI 10.1016/j.ibiod.2015.03.033. [Google Scholar] [CrossRef]
26. Bari, E., Schmidt, O., Oladi, R. (2015). A histological investigation of Oriental beech wood decayed by Pleurotus ostreatus and Trametes versicolor. Forest Pathology, 45, 349–57b. DOI 10.1111/efp.12174.
27. Barreto, R. J. A., Anaguano, H. A. (2014). Evaluación del crecimiento y compatibilidad de hongos de la podredumbre blanca. Ciencia en Desarrollo, 5, 197–205. [Google Scholar]
28. American Wood Preservers’ Association Standard E10-01. (2003). Standard method of testing wood preservatives by laboratory soil-block culture. American Wood Preservers’ Association Book of Standards, 419–429. [Google Scholar]
29. Green, B., Jones, P. D., Nicholas, D. D., Schimleck, L. R., Shmulsky, R. (2011). Non-destructive assessment of Pinus spp. wafers subjected to Gloeophyllum trabeum in soil block decay tests by diffuse reflectance near infrared spectroscopy. Wood Science and Technology, 45(3), 583–595. DOI 10.1007/s00226-010-0368-9. [Google Scholar] [CrossRef]
30. Prislan, P., Gričar, J., Čufar, K. (2014). Wood sample preparation for microscopic analysis. University of Ljubljana: Department of Wood Science and Technology, 1–8. [Google Scholar]
31. Farnet, A. M., Chevremont, A. C., Gil, G., Gastaldi, S., Ferre, E. (2011). Alkylphenol oxidation with a laccase from a white-rot fungus: Effects of culture induction and of ABTS used as a mediator. Chemosphere, 82(2), 284–289. DOI 10.1016/j.chemosphere.2010.10.001. [Google Scholar] [CrossRef]
32. Xu, J., Yang, Q. (2010). Isolation and characterization of rice straw degrading Streptomyces griseorubens C-5. Biodegradation, 21(1), 107–116. DOI 10.1007/s10532-009-9285-8. [Google Scholar] [CrossRef]
33. Chan, C. W., Heredia, A. G. P., Rodríguez, V. R. (2016). Aislamiento y evaluación de la actividad enzimática ligninolítica de macromicetos del estado de Veracruz, México. Revista Internacional de Contaminación Ambiental, 32(3), 339–351. DOI 10.20937/RICA.2016.32.03.08. [Google Scholar] [CrossRef]
34. Tišma, M., Žnidaršič, P. P., Vasić, R. Đ., Zelić, B. (2012). Optimization of laccase production by Trametes versicolor cultivated on industrial waste. Applied Biochemistry and Biotechnology, 166(1), 36–46. DOI 10.1007/s12010-011-9401-1. [Google Scholar] [CrossRef]
35. Selbmann, L., Egidi, E., Isola, D., Onofri, S., Zucconi, L. et al. (2013). Biodiversity, evolution and adaptation of fungi in extreme environments. Plant Biosystems—An International Journal Dealing with all Aspects of Plant Biology, 147(1), 237–246. DOI 10.1080/11263504.2012.753134. [Google Scholar] [CrossRef]
36. Meena, R. K., Dutt, B., Sharma, K. R., Sharma, J. N., Kumar, R. (2017). Effect of plant extracts on Trametes versicolor (White rot) fungal colonization and inhibition of treated wood samples of Pinus roxburghii Sargent. Journal of Entomology and Zoology Studies, 5, 574–580. [Google Scholar]
37. Jaber, S. M., Shah, U. K. M., Asa’ari, A. Z. M., Ariff, A. B. (2017). Optimization of laccase production by locally isolated Trichoderma muroiana IS1037 using rubber wood dust as substrate. BioResources, 12(2), 3834–3849. DOI 10.15376/biores.12.2.3834-3849. [Google Scholar] [CrossRef]
38. Raseda, N., Hong, S., Kwon, O. Y., Ryu, K. (2014). Kinetic evidence for the interactive inhibition of laccase from Trametes versicolor by pH and chloride. Journal of Microbiology and Biotechnology, 24(12), 1673–1678. DOI 10.4014/jmb.1408.08012. [Google Scholar] [CrossRef]
39. Kim, B., Han, J. W., Ngo, M. T., Dang, Q. L., Kim, J. C. et al. (2018). Identification of novel compounds, oleanane-and ursane-type triterpene glycosides, from Trevesia palmata: Their biocontrol activity against phytopathogenic fungi. Scientific Reports, 8(1), 1–11. DOI 10.1038/s41598-017-17765-5. [Google Scholar] [CrossRef]
40. Ligon, J. M., Hill, D. S., Hammer, P. E., Torkewitz, N. R., Hofmann, D. et al. (2000). Natural products with antifungal activity from Pseudomonas biocontrol bacteria. Pest Management Science, 56, 688–695. DOI 10.1002/1526-4998(200008)56:8<688::AID-PS186>3.0.CO;2-V.
41. Toral, L., Rodríguez, M., Béjar, V., Sampedro, I. (2018). Antifungal activity of lipopeptides from Bacillus XT1 CECT, 8661 against Botrytis cinerea. Frontiers in Microbiology, 9, 749. DOI 10.3389/fmicb.2018.01315.
42. Zouari, I., Jlaiel, L., Tounsi, S., Trigui, M. (2016). Biocontrol activity of the endophytic Bacillus amyloliquefaciens strain CEIZ-11 against Pythium aphanidermatum and purification of its bioactive compounds. Biological Control, 100, 54–62. DOI 10.1016/j.biocontrol.2016.05.012. [Google Scholar] [CrossRef]
43. Agoramoorthy, G., Chandrasekaran, M., Venkatesalu, V., Hsu, M. J. (2007). Antibacterial and antifungal activities of fatty acid methyl esters of the blind-your-eye mangrove from India. Brazilian Journal of Microbiology, 38(4), 739–742. DOI 10.1590/S1517-83822007000400028. [Google Scholar] [CrossRef]
44. Liu, W., Zhu, B., Mu, W., Liu, F. (2008). Antifungal activities and components of VOCs produced by bacillus subtilis G8. Current Research in Bacteriology, 1(1), 28–34. DOI 10.3923/crb.2008.28.34. [Google Scholar] [CrossRef]
45. Giorgio, A., Stradis, A. D., Cantore, P. L., Lacobellis, N. S. (2015). Biocide effects of volatile organic compounds produced by potential biocontrol rhizobacteria on Sclerotinia sclerotiorum. Frontiers in Microbiology, 6, 114. DOI 10.3389/fmicb.2015.01056. [Google Scholar] [CrossRef]
46. Esmaeel, Q., Pupin, M., Jacques, P., Leclère, V. (2018). Nonribosomal peptides and polyketides of Burkholderia: new compounds potentially implicated in biocontrol and pharmaceuticals. Environmental Science and Pollution Research, 25(30), 29794–29807. DOI 10.1007/s11356-017-9166-3. [Google Scholar] [CrossRef]
47. Ongena, M., Jacques, P., Touré, Y., destain, J., Jabrane, A. et al. (2005). Involvement of fengycin-type lipopeptides in the multifaceted biocontrol potential of Bacillus subtilis. Applied Microbiology and Biotechnology, 69(1), 29–38. DOI 10.1007/s00253-005-1940-3. [Google Scholar] [CrossRef]
48. Chan-Cheng, M., Cambronero-Heinrichs, J. C., Masís-Mora, M., Rodríguez-Rodríguez, C. E. (2020). Ecotoxicological test based on inhibition of fungal laccase activity: Application to agrochemicals and the monitoring of pesticide degradation processes. Ecotoxicology and Environmental Safety, 195, 110419. DOI 10.1016/j.ecoenv.2020.110419. [Google Scholar] [CrossRef]
49. Jo, W. S., Kang, M. J., Choi, S. Y., Yoo, Y. B., Seok, S. J. et al. (2010). Culture conditions for mycelial growth of Coriolus versicolor. Mycobiology, 38(3), 195–202. DOI 10.4489/MYCO.2010.38.3.195. [Google Scholar] [CrossRef]
50. Black, B. A., Zannini, E., Curtis, J. M., Gï, M. G. (2013). Antifungal hydroxy fatty acids produced during sourdough fermentation: Microbial and enzymatic pathways, and antifungal activity in bread. Applied and Environmental Microbiology, 79(6), 1866–1873. DOI 10.1128/AEM.03784-12. [Google Scholar] [CrossRef]
51. Morel, M., Meux, E., Mathieu, Y., Thuillier, A., Chibani, K. et al. (2013). Xenomic networks variability and adaptation traits in wood decaying fungi. Microbial Biotechnology, 6(3), 248–263. DOI 10.1111/1751-7915.12015. [Google Scholar] [CrossRef]
52. Takasaki, K., Shoun, H., Yamaguchi, M., Takeo, K., Nakamura, A. et al. (2004). Fungal ammonia fermentation, a novel metabolic mechanism that couples the dissimilatory and assimilatory pathways of both nitrate and ethanol. Role of acetyl CoA synthetase in anaerobic ATP synthesis. Journal of Biological Chemistry, 279(13), 12414–12420. DOI 10.1074/jbc.M313761200. [Google Scholar] [CrossRef]
53. Ahmed, S. A., Morén, T., Sehlstedt-Persson, M., Blom, Å. (2017). Effect of oil impregnation on water repellency, dimensional stability and mold susceptibility of thermally modified European aspen and downy birch wood. Journal of Wood Science, 63(1), 74–82. DOI 10.1007/s10086-016-1595-y. [Google Scholar] [CrossRef]
54. Allen, J. L. (2013). Basics of compounding with tars. International Journal of Pharmaceutical Compounding, 17, 400–140. [Google Scholar]
55. Agency for Toxic Substances and Disease Registry (ATSDR). (2020). Atlanta, Georgia, is a federal public health agency of the USA. Department of Health and Human Services, https://www.atsdr.cdc.gov/toxguides/index.asp#bookmark05. [Google Scholar]
![]() | This work is licensed under a Creative Commons Attribution 4.0 International License, which permits unrestricted use, distribution, and reproduction in any medium, provided the original work is properly cited. |